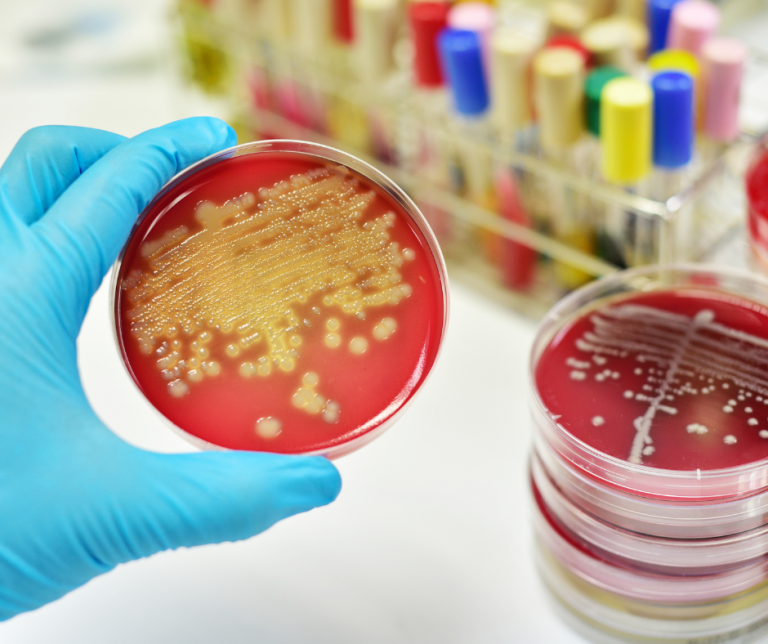
Sepsa – groźna reakcja na zakażenie

Sepsa, zwana też posocznicą lub endotoksemią, to zagrażający życiu stan, w którym organizm reaguje nadmiernie na zakażenie drobnoustrojami. Sepsa nie jest samodzielną chorobą, ale zespołem objawów, które mogą prowadzić do niewydolności wielu narządów i śmierci. Jakie są przyczyny, objawy i leczenie sepsy? Jak można jej zapobiegać?
Sepsa – przyczyny
Sepsa może być wywołana przez różne rodzaje drobnoustrojów, takie jak bakterie, wirusy lub grzyby. Najczęściej sepsa rozwija się na skutek zakażenia bakteryjnego, które nie zostało odpowiednio leczone lub rozszerzyło się na cały organizm. Bakterie mogą dostać się do krwiobiegu przez rany, infekcje skóry, zapalenia płuc, zapalenia opon mózgowo-rdzeniowych, zapalenia wyrostka robaczkowego lub innych narządów wewnętrznych. W krwiobiegu bakterie uwalniają toksyny, które wywołują silną reakcję zapalną organizmu. Ta reakcja może zaburzać pracę serca, naczyń krwionośnych, płuc, nerek, wątroby i innych narządów.
Sepsa – objawy
Objawy sepsy mogą być różne w zależności od rodzaju zakażenia i stopnia zaawansowania choroby. Niektóre z typowych objawów sepsy to:
- wysoka gorączka lub niska temperatura ciała
- przyspieszone tętno i oddech
- spadek ciśnienia krwi
- dreszcze i dreszcze
- bóle mięśni i stawów
- nudności i wymioty
- biegunka
- zaburzenia świadomości, splątanie, senność
- czerwone plamki lub wybroczyny na skórze, które nie blakną pod naciskiem
- zaburzenia krzepnięcia krwi i krwawienia
Objawy sepsy mogą być mylone z innymi chorobami, dlatego ważne jest szybkie rozpoznanie i leczenie. Im wcześniej rozpocznie się leczenie sepsy, tym większe są szanse na przeżycie i uniknięcie powikłań.
Sepsa – leczenie
Leczenie sepsy polega na zwalczaniu zakażenia i podtrzymywaniu funkcji życiowych organizmu. Leczenie sepsy odbywa się w szpitalu, najczęściej na oddziałach intensywnej terapii. Podstawowym elementem leczenia sepsy jest podawanie antybiotyków dożylnie lub domięśniowo. Antybiotyki powinny być dobrane w zależności od rodzaju drobnoustroju wywołującego zakażenie. Antybiotyki powinny być podawane jak najszybciej po rozpoznaniu sepsy, najlepiej w ciągu pierwszej godziny.
Oprócz antybiotyków pacjenci z sepsą otrzymują także płyny dożylnie, aby poprawić krążenie krwi i zapobiec odwodnieniu. W razie potrzeby podaje się także leki podnoszące ciśnienie krwi, leki przeciwzapalne, leki przeciwgorączkowe i leki przeciwbólowe. Jeśli sepsa doprowadziła do niewydolności narządów, stosuje się także inne metody leczenia, takie jak dializa nerek, wentylacja mechaniczna płuc czy transfuzja krwi.
Sepsa – zapobieganie
Zapobieganie sepsie polega głównie na unikaniu zakażeń i leczeniu ich w odpowiednim czasie. Niektóre z zaleceń dotyczących zapobiegania sepsie to:
- dbanie o higienę osobistą i otoczenia
- unikanie kontaktu z osobami chorymi lub zakażonymi
- stosowanie antybiotyków zgodnie z zaleceniami lekarza i nie przerywanie leczenia przed czasem
- regularne wykonywanie badań kontrolnych i profilaktycznych
- szczepienie się przeciwko niektórym bakteriom, które mogą powodować sepsę, np. meningokokom, pneumokokom czy pałeczce hemofilnej typu B
- wzmacnianie odporności organizmu przez zdrowy tryb życia, odpowiednią dietę i aktywność fizyczną
Sepsa jest poważnym stanem, który może być śmiertelny. Dlatego ważne jest, aby znać jej objawy i jak najszybciej zgłosić się do lekarza w razie podejrzenia sepsy. Im wcześniej rozpocznie się leczenie sepsy, tym większe są szanse na przeżycie i uniknięcie powikłań. Zapobieganie sepsie polega na unikaniu zakażeń i leczeniu ich w odpowiednim czasie. Niektóre szczepienia mogą także chronić przed sepsą wywołaną przez niektóre bakterie.